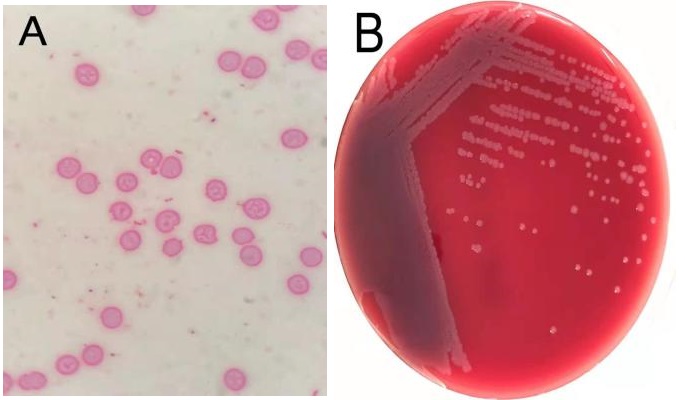

“Balneatrix alpica”菌名翻译为“阿尔卑斯浴者菌”,亦有翻译为“高山浴者菌”,存在于环境水源中,属于机会致病菌。1987年曾导致法国阿尔卑斯山脉温泉水疗者大规模暴发肺炎和脑膜炎而得名[1]。现将本院收治的一名重症肺炎患者,血及胸腔积液中均培养出不知名革兰氏阴性杆菌,经最终菌种DNA鉴定,明确诊断为阿尔卑斯浴者菌。我国目前尚无该菌报告病例,现将该患者诊疗过程进行总结分析。
1 资料与方法男性,62岁,因“咳嗽咳痰伴发热5 d,气促2 d”于2021年1月26日就诊本科。1月21日患者淋雨后出现咳嗽咳痰,咳淡黄色黏痰,多次发现痰中带血,量少,性质黏稠,不易咳出,伴有发热,Tmax37.5℃,服用阿奇霉素、对乙酰氨基酚症状未见好转。1月24日出现气促,不能平卧,端坐稍缓解,无畏寒寒战等其他不适,1月26日就诊急诊科,查体:T 36.2℃,P 123次/min,R 35次/min,BP 146/94 mmHg (1 mmHg=0.133 kPa),SPO2:90%(FiO2:40%)。神志清醒,半卧位。双肺呼吸音粗,右中上肺可闻及湿性啰音,右下肺呼吸音弱,左肺未闻及明显干湿性啰音。心率123次/min,律齐,各瓣膜听诊区未闻及病理性杂音。四肢肌力正常,双下肢凹陷性水肿,余查体无异常。实验室检查:白细胞15.96×109/L; 血小板85×109/L; 中性细胞比率95.7%;C反应蛋白>200 mg/L; 降钙素原15.05 ng/mL; 血气:pH 7.345;二氧化碳分压30.4 mmHg; 氧分压60.3 mmHg; 碳酸氢根16.2 mmol/L; 乳酸4.58 mmol/L; 生化:钠129 mmol/L; 尿素9.80 mmol/L; 白蛋白26.00 g/L; 总胆红素51 μmol/L; 直接胆红素25 μmol/L; BNP 7384 ng/mL; 凝血:凝血酶原时间15.10 s; 国际标准化比值1.37;纤维蛋白原9.95 g/L; 肺部CT提示双肺多发渗出及实变,以右肺为重,右侧胸腔少量积液。综上检查SOFA评分为7分,依据脓毒症3.0诊断标准[2],考虑“脓毒症-重症肺炎”收入EICU住院治疗。既往高血压病史10余年,血压控制在110/70 mmHg。个人史抽烟30余年,10根/d。在海口某小区任保安,无出岛旅居史,无接触及饲养动物史。
入院诊断:①重症肺炎、呼吸衰竭、胸腔积液;②脓毒症;③急性心力衰竭;④乳酸酸中毒;⑤低蛋白血症。入EICU后给予经鼻高流量氧疗纠正呼吸衰竭[3],完善痰、血等病原学检查。感染方面给予美罗培南1 g/8 h联合多西环素0.1 g/12 h抗感染;循环方面给予利尿,精准液体管理纠正心衰,以及补充白蛋白等对症支持治疗。病原菌方面:呼吸道感染病源体IGM九联、病毒等检测均为阴性,痰涂片未见致病菌。1月28日微生物室报患者血培养双瓶需氧瓶均为G-杆菌,本院实验室鉴定不出菌种,外送标本行菌种DNA靶向测序。
患者经过近1周治疗,临床症状较前好转,心衰纠正,炎症指标明显下降,于1月31日体温正常后转普通病房。感染方面美平降级为头孢派酮舒巴坦,继续多西环素治疗。2月2日外送标本DNA测序鉴定为Balneatrix alpica,即阿尔卑斯浴者菌。后续患者出现胸膜炎性胸痛,间断气促,复查肺部CT提示右侧胸腔积液量增多,给予穿刺引流,胸水外送经DNA鉴定报高山巴氏发菌,即Balneatrix alpica,至此患者感染的病原菌明确,考虑此菌为少见菌,对抗菌药物敏感性较高,后续抗生素方案降解为左氧氟沙星500 mg/d,经治疗3周后患者出院,后期随访追踪无不适。

|
| 图 1 1月26日首次就诊胸部CT平扫 |
|
|

|
| 图 2 2月1日复查胸部CT平扫 |
|
|

|
| 图 3 2月22日出院胸部CT平扫 |
|
|

|
| 图 4 3月23日(出院1个月后复查胸部CT平扫) |
|
|
|
| 图 5 Balneatrix alpicaca菌涂片 |
|
|

|
| 图 6 血菌种DNA鉴定结果 |
|
|

|
| 图 7 胸水菌种DNA鉴定结果 |
|
|
1987年,法国的一家温泉浴场(37℃)发生了一次由以前未描述的革兰氏阴性杆菌引起的感染暴发。共计35例肺炎和2例脑膜炎, 从8例患者的血液、脑脊液和痰中分离出菌株,从水中分离出1株[1, 4]。所有9个分离株都具有相同的rRNA基因转录模式,构成紧密的DNA杂交群,rRNA-DNA杂交和16SrRNA测序表明,所研究的细菌在蛋白细菌超家族Ⅱ(γ亚群)中表现出一个新的分支,接近海洋螺旋菌属。故为研究的生物体命名为Balneatrix alpica。流行病学资料表明,热水是感染源。这些患者中没有一例死亡。70岁以上患者和男性患者的发病率明显较高,人们认为没有发生人与人之间的传播。这一突发事件强调了加强对温泉水疗患者感染监测的必要性[5]。
本例患者居住在海口澄迈县一温泉小镇,仔细询问患者有每日泡温泉习惯,发病前患者右小腿有蚊子叮咬后皮肤挠破情况,结合患者发病前有淋雨免疫功能低下状况,分析发病的可能原因为患者泡温泉时该菌从小腿皮肤入血,侵袭呼吸系统,导致肺炎、脓毒症,各器官损害。后续本院微生物工作人员去该小区温泉反复调查取样,最终成功培养出和该患者相同的菌种DNA序列,至此该患者重症肺炎的流行病学史明确,病因清楚,诊疗效果较好。搜索文献目前为止我国还没有报道该菌导致肺部感染病例。仔细追问患者同小区未有和他同样症状患者。考虑原因如下,首先、环境因素:该菌存在于温泉水源中,患者皮肤黏膜屏障破损为细菌入侵提供了可能。其次、宿主因素:机体免疫力低下更容易被感染[6]。再次、医院因素:不排除有些患者就诊社区医院,没有完善血、痰等病原微生物检查,或者实验室条件所限,没有查到病原菌,且此菌少见,影像学类似大叶性肺炎,经验性抗菌治疗效果好,故鲜有报道。最后、对于疑似脓毒症患者,应用抗菌药物前规范采取血培养可以提高阳性检出率[7],有助于后续病原诊断及精准治疗。
该病例尚有疑惑之处,为什么仅仅侵及右肺?国外文献报道从10例患者中分离出此菌,在这些患者中观察到两种临床形式。其中肺炎8例。最早的症状为寒战、39 ℃以上的迅速发热、胸膜炎性胸痛、咳血和多产性咳嗽。所有病例的胸片均不正常,表现为单侧大叶浸润或实变。化脓性脑膜炎2例。一组与肺炎有关,另一组没有呼吸体征。实验室分析显示每mm3白细胞计数超过10 000。分离菌由3个不同的实验室从2次连续的血液培养(8例患者)、呼吸道分泌物(1例患者)和脑脊液(2例患者)中回收。每个病例的军团菌、衣原体、立克次体和支原体血清学检测均为阴性[5]。对比国外病例临床特征,我国病例在临床特征上表现的发热、咳血、胸膜炎性胸痛及单侧大叶浸润都比较相似。遗憾的是该患者抗菌药物应用后症状改善明显,痰比较少,没有进行纤维支气管镜留取痰标本进一步佐证。
识别脓毒症感染病原和感染部位一直是脓毒症研究的热点问题,关系到抗生素的选择和器官支持策略的实施[8]。急诊科患者感染的病原菌构成复杂,大多数患者病情急、重、进展迅速,不确定性突出,要求急诊医师在很短的时间内利用有限的信息做出正确临床决策,这始终是一个重大挑战[9]。
利益冲突 所有作者声明无利益冲突
作者贡献声明 郑永先:文献检索、文章撰写;卢学俊:检查数据收集和整理;吴泽:病历检索及患者追踪。
| [1] | Dauga C, Gillis M, Vandamme P, et al. Balneatrix alpica gen. nov., sp. nov., a bacterium associated with pneumonia and meningitis in a spa therapy center[J]. Res Microbiol, 1993, 144(1): 35-46. DOI:10.1016/0923-2508(93)90213-l |
| [2] | 中国医疗保健国际交流促进会急诊医学分会, 中华医学会急诊医学分会, 中国医师协会急诊医师分会, 等. 中国脓毒症早期预防与阻断急诊专家共识[J]. 中华急诊医学杂志, 2020, 29(7): 885-895. DOI:10.3760/cma.j.issn.1671-0282.2020.07.001 |
| [3] | 中国医师协会急诊医师分会, 中华医学会急诊医学分会, 中国急诊专科医联体, 等. 急诊成人经鼻高流量氧疗临床应用专家共识[J]. 中华急诊医学杂志, 2021, 30(9): 1041-1050. DOI:10.3760/cma.j.issn.1671-0282.2021.09.001 |
| [4] | Casalta JP, Peloux Y, Raoult D, et al. Pneumonia and meningitis caused by a new nonfermentative unknown gram-negative bacterium[J]. J Clin Microbiol, 1989, 27(7): 1446-1448. DOI:10.1128/jcm.27.7.1446-1448.1989 |
| [5] | Hubert B, de Mahenge A, Grimont F, et al. An outbreak of pneumonia and meningitis caused by a previously undescribed gram-negative bacterium in a hot spring spa[J]. Epidemiol Infect, 1991, 107(2): 373-381. DOI:10.1017/s0950268800049013 |
| [6] | 赵微, 卞雯, 胡怡倩, 等. 急诊细菌感染患者病原学及抗菌药物应用特点[J]. 中华医院感染学杂志, 2021, 31(10): 1507-1511. DOI:10.11816/cn.ni.2021-202361 |
| [7] | 闫圣涛, 何秀燕, 孙力超, 等. 降钙素原在血流感染病原学诊断中的价值[J]. 中华急诊医学杂志, 2021, 30(4): 426-431. DOI:10.3760/cma.j.issn.1671-0282.2021.04.009 |
| [8] | 高玉雷, 刘艳存, 王力军, 等. 天津某三甲医院四年急诊脓毒症特点回顾分析[J]. 中华急诊医学杂志, 2022, 31(1): 85-91. DOI:10.3760/cma.j.issn.1671-0282.2022.01.016 |
| [9] | 陈旭岩. 急诊抗感染治疗的常见误区[J]. 中国实用内科杂志, 2021, 41(3): 186-189. DOI:10.19538/j.nk2021030103 |
 2022, Vol. 31
2022, Vol. 31



